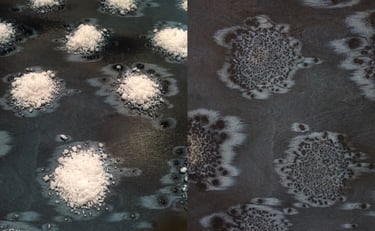

Refined finishes for a Timeless touch of Luxury
Curoq’s designs are a tribute to the raw beauty of nature. Inspired by the textures of stone, wood, and natural fibers, each piece reflects the timeless elegance of handcrafted luxury. Our curated collections celebrate the tactile connection between human touch and the finest materials, creating an experience that goes beyond visual design.
Every creation is meticulously crafted by master artisans, blending innovation with tradition to bring nature’s beauty into the heart of luxury interiors.
Designed by Hadi Teherani, these aluminum textures embody the metallic beauty of aluminum—spectacular, structured, and stylish. They introduce a new dimension of surface design that is both original and versatile, offering innovative solutions for sophisticated architectural spaces.




The Native collection by Hadi Teherani captures the essence of raw aluminum in primal, textured finishes—Saturn, Neptune, and Pluto. With unrefined cast surfaces and options like matte, brushed, or anodized, Native brings a natural, archaic beauty to interiors and facades in tones from graphite to silvery bright and rich bordeaux.




The Glamour collection by Hadi Teherani reimagines aluminum with high-gloss, galvanized surfaces that shine with metallic hues and radiant reflections. Featuring structures like Saturn, Neptune, and Pluto, it brings an iridescent, luxurious finish to interior spaces, elevating aluminum with an extraordinary elegance.


Design and fine craftsmanship for fabric wall coverings
Hand painted silk wall coverings and precious embroidery showcase an exquisite beauty that captivates the senses. The intricate brushstrokes on the silk create a mesmerizing tapestry of colors and patterns, transforming any space into a work of art. The delicate embroidery, meticulously crafted with skillful hands, adds an extra layer of opulence and elegance. Each stitch tells a story, with carefully chosen motifs and motifs that reflect the rich cultural heritage and artistic traditions. The combination of these two art forms creates a harmonious symphony of texture and design, enhancing the aesthetic appeal of any interior. The interplay of vibrant hues and intricate details invites a sense of luxury and refinement, making these hand painted silk wall coverings and precious embroidery a truly enchanting addition to any home or space.
Curated Artmosaics
Curoq's focus on divine details in our curated mosaics speaks to the meticulous craftsmanship and attention to detail that goes into creating these works of art. Each mosaic is a testament to the skill and artistry of the craftsmen who meticulously arrange and set each individual piece, resulting in a breathtaking display of intricate patterns and rich textures.The incorporation of luxury and noble materials in mosaic art allows for the creation of bespoke, one-of-a-kind designs that can serve as focal points within a space, adding a sense of exclusivity and refinement. Whether used in grand architectural features or as decorative accents, these curated mosaics have the power to transform interiors, evoking a sense of luxury and timeless beauty.






Blending tradition with innovation, AB+AC Architects craft emotive designs with Fantini.Their ‘Back to the Future’ installation redefines mosaics and terrazzo, showcasing timeless artistry with modern vision.




Nature and New Geometries




Palladian Mosaic Reimagined blends classical symmetry with organic forms, incorporating mother of pearl, marble, and mirrored glass for a timeless yet modern aesthetic.



Anne-Marie Fischer x Fantini Moisaici




Our collections are a composition of inspirations coming alive through the interpretation of authentic materials ranging from beautiful natural stones, to colorful venetian glass, to luminescent mother of pearl, to true Italian terrazzo to distinct metals for a personalized finishing touch. Celebrate creative freedom. Be inspired.






The Art of Mosaics,perfected by Curoq


At Curoq we are thrilled to introduce a stunning collection of high-quality marble from Italian quarries. This noble material is renowned for its timeless beauty and durability. Our series of geometric and three-dimensional surfaces offer a sophisticated and elegant touch to any space. These technically high-grade marbles have been used in iconic projects around the world, such as the Louvre in Abu Dhabi and the Twin Towers. Elevate your interior design with the luxury and sophistication of our marble collection, adding a touch of elegance to any environment. Experience the timeless beauty and prestige of Italian marble with Curoq.
Curated Marble
Floor in Pietra di Luserna in flamed technique


Inspired by the Apuan Alps, this design reflects the harmony between nature and material. Like fallen leaves, delicate inlaid wood fragments land on honed marble, evoking the rhythm of water-washed stone. Each piece tells a story—of journeys, landscapes, and timeless craftsmanship.


Design by Zuber&Salzmann
CUROQ presents exclusive ZUBER & SALZMANN wallpaper editions—where heritage craftsmanship meets contemporary luxury. ZUBER, the world’s oldest wallpaper maker, creates hand-blocked panoramas of timeless beauty, while SALZMANN redefines bespoke wall coverings with artistic innovation.
ZUBER & SALZMANN: Collectible Wallpaper Editions at Curoq


Curoq offers a wide range of designer editions that go beyond traditional wallpapers. With an extensive collection of unique designs, At Curoq we allow you to transform your walls into stunning works of art. Whether you prefer bold and vibrant patterns or subtle and elegant motifs, there is a designer edition to suit every style and taste. These exclusive designs are carefully curated to bring a touch of sophistication and luxury to any space. From intricate details to modern and abstract compositions, Curoq's designer editions allow you to personalize your interiors and create a truly unique atmosphere. Elevate your home or office decor with the exquisite selection of designer editions available at Curoq.
LOOKBOOK

Architectural surfaces


At Curoq we specialize in curating architectural surfaces that are meticulously designed and crafted to elevate any space. With a keen eye for detail and a passion for creativity, we carefully select surfaces that showcase the perfect blend of aesthetics and functionality. From luxurious marble countertops to sleek and contemporary glass facades, each surface is chosen to enhance the architectural beauty and elegance of any project. Understanding the importance of quality and durability and ensuring that every surface is made to withstand the test of time. Whether you're looking for sophisticated surfaces for a residential project or durable materials for a commercial space,at Curoq we offer a curated collection that caters to your unique style and vision.






Signed Textures
Italian craftsmanship is at the heart of our new collection, bringing a fresh and innovative perspective to surface design. Our signature textures are carefully etched onto natural stones and porcelain, creating a stunning and artistic look for both wall and floor coverings. Each piece is a masterpiece of Italian workmanship, with meticulous attention to detail and a range of exquisite finishes. Our collection brings a new level of creativity and sophistication to interior design, offering a unique and timeless aesthetic for any space.Experience the mastery of Italian artistry and elevate your surroundings with our exquisite designs.
Japanese artistry
Curoq has introduced Japanese editions in collaboration, featuring authentic Japanese styles, textures, and refined techniques. These high-quality mosaics are meant for bespoke surfaces in luxurious settings, offering a touch of sophistication and elegance. These mosaics from Japan bring a sense of tradition and craftsmanship to any space, adding a unique and timeless aesthetic.Discover unfaltering quality and design that are perfect for creating a luxurious and distinguished atmosphere in any interior design project.






The Art of Stillness in Every Line
YOROI × YUKASUMI is a study in refined contrast—where sculptural reliefs emerge from flat surfaces, and the interplay of deep red and charcoal black creates a tonal balance that feels both deliberate and instinctive. Inspired by the quiet discipline of Japanese Zen, this surface invites stillness, depth, and shadow into architectural space




Urushi
The ancient techniques of urushi lacquer finishes have been reintroduced to modern craftsmen, allowing for the creation of stunning and durable objects. This traditional Japanese method involves the use of urushi tree sap, which is harvested and refined to create a lustrous and hard-wearing lacquer. The finish is applied in multiple layers, each carefully polished to achieve a smooth and glossy surface. This time-honored technique not only enhances the natural beauty of wood or other materials, but also provides protection against wear and tear. The art of urushi lacquer finishes is a testament to the skill and patience of artisans, as it requires precision and attention to detail. By embracing these ancient techniques, contemporary artisan Sergej is able to create timeless pieces that are both visually striking and long-lasting.








Exquisite Italian Lacquer Finishes
At Curoq, we bring to you the allure of masterfully crafted Italian lacquer finishes that transform spaces with an unparalleled sense of elegance and refinement. Each finish is meticulously produced using traditional Italian techniques, ensuring a flawless surface with a rich, lustrous sheen. Our lacquer finishes are not just coatings; they are artistic statements of sophistication, adding depth and warmth to every surface they touch.




Numen is characterized by a meticulous craftsmanship of the highest quality of enamelled porcelain.
Numen -Design Doriana E Massimiliano Fuksas




The Cadenza collection, born from Kejun Li’s engineering mindset, challenges the traditional concept of ‘one tile, one design’ with its modular, identical tiles that transform when combined. Inspired by the tile-based game Tantrix and the intricate patterns of M.C. Escher, CADENZA blends mathematical precision with artistic flair.
It’s an innovative approach to tile design, offering a unique, creative space for architectural expression.


Creative Ideas with Wood
At Curoq, we celebrate the timeless beauty of wood, transforming it into innovative designs that inspire. From bespoke furniture to feature walls, wood becomes a canvas for creativity, offering warmth, texture, and endless possibilities.








Salt-Infused Artistry
In collaboration with Ania Bauer and Jacob Brinck, Curoq transforms wood surfaces through the natural osmosis of salt. As salt absorbs moisture and pigments, it creates unique patterns that follow the wood’s natural grain, blending nature’s rhythm with innovative design. Explore this exclusive craft at Curoq.

Mood Boards




If you're looking for inspirations for your projects, we've got just the thing for you! Our mood boards are the perfect source of creative ideas and can help you bring your vision to life. Designing a new project? Our carefully curated mood boards will ignite your creativity and provide you with a visual guide. Each board is filled with captivating objects, colors, textures, and patterns that will spark your imagination and help you explore different aesthetics. Explore our Mood board gallery.































